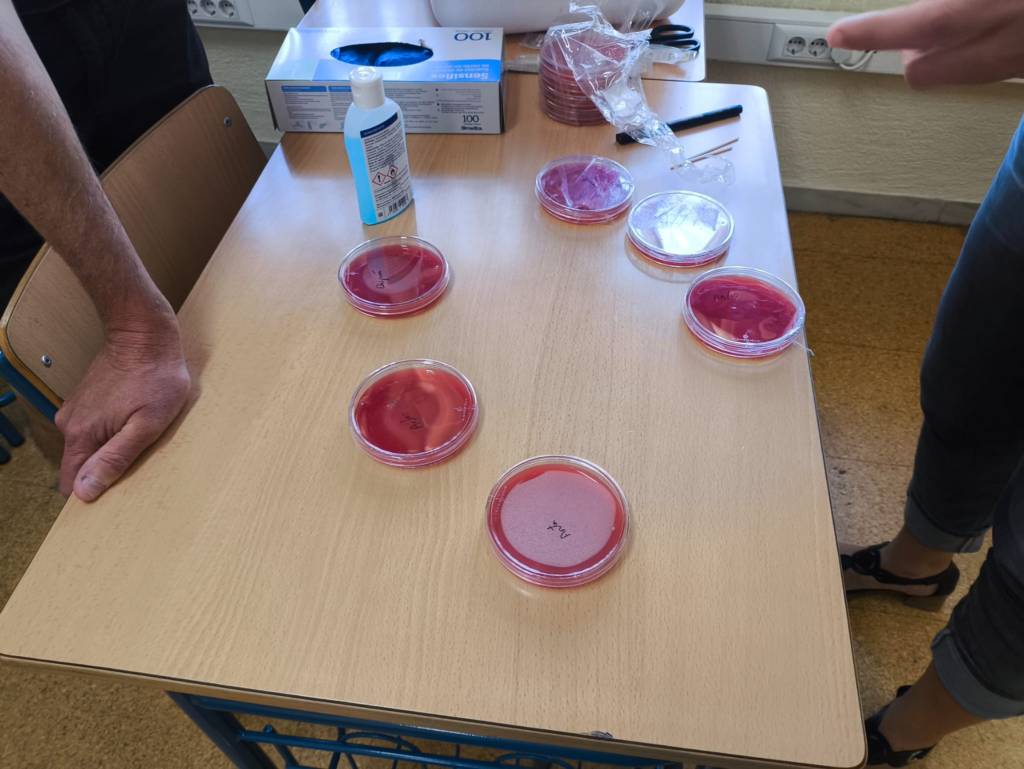

El día 26 de septiembre de 2025 nuestro alumnado de 1º y 2º bachillerato de Ciencias de la Salud participó en el taller Prevenir está en tus manos, organizado por la Universidad de Almería junto al Hospital Universitario Poniente y enmarcado dentro de las actividades de la Noche Europea de los Investigadores. El taller fue impartido por la doctora Reyes Álvarez-Ossorio, la doctora Silvia Vallejo y el doctor Joaquín Salas, integrantes del Grupo de Investigación en Salud Internacional de Almería (Grupo GISIA).
El objetivo de este taller era dar a conocer el papel de las manos como vehículo de transmisión de microorganismos en entornos como centros sanitarios o en cuidados a personas especialmente vulnerables. Una adecuada higiene de manos se considera la estrategia más sencilla y efectiva para prevenir esta transmisión, por lo que las manos limpias pueden salvar vidas. De ahí la importancia de aprender a realizar de manera correcta el lavado de manos y la higiene, algo que hacemos cotidianamente y que cobró una gran importancia en la pandemia por COVID19.
El taller se llevó a cabo en dos sesiones. El lunes 22 de septiembre, la doctora Silvia Vallejo, trajo algunos medios de cultivo de microorganismos, como el agar sangre, y cuatro voluntarios procedieron a realizar siembras de sus manos en dichos medios. Una directamente colocando los dedos sobre el agar, y la otra con los mismos dedos pero después de ser lavados con gel hidroalcohólico.
El segundo día, viernes 26 de septiembre, el taller constó de una introducción teórica con un breve repaso histórico de las personas que contribuyeron al avance de la medicina en materia de infecciones, como Ignaz Semmelweis, conocido como ”el salvador de madres”, Louis Pasteur, John Snow, Joseph Lister… Fue muy ameno y el alumnado participó activamente.
A continuación se repasaron los mecanismos de transmisión de las enfermedades infecciosas y el papel de las manos como vehículo de transmisión de muchas de ellas, especialmente en aquellas producidas por microorganismos multirresistentes y que representan un auténtico problema de salud pública en el momento actual. Posteriormente se observaron los cultivos recogidos el lunes 22 de septiembre y que pusieron de manifiesto como el lavado previo de manos con gel hidroalcohólico disminuía sustancialmente el número de colonias bacterianas que crecieron en dichos cultivos.
Se dieron también indicaciones sobre cómo realizar un adecuado lavado e higiene de manos que finalmente pusimos en práctica con música de fondo de Taylor Swift (shake it off).
Queremos agradecer a la doctora Reyes Álvarez-Ossorio, la doctora Silvia Vallejo y el doctor Joaquín Salas, su implicación en el desarrollo de este taller a nuestro alumnado de 1º y 2º bachillerato de ciencias.